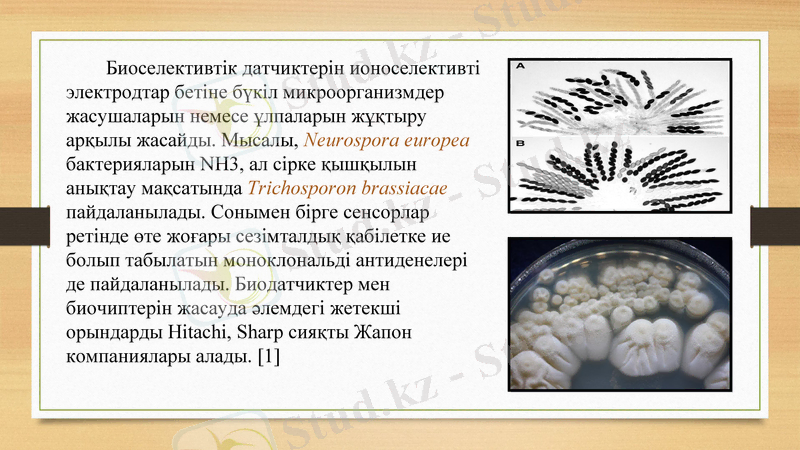
Slide 6

Ферменттер негізіндегі датчиктер мен биочиптер: құрылымы, қолданылуы және энзимодиагностика



Тақырыбы: Фермент негізіндегі датчиктер құруды және диагностиканы жетілдеру үшін ферменттер қолдану
Тексерген:

Жоспар:
Кіріспе
Биоэлектроника
Биологиялық микрочиптер
Протоемика
Ферменттік негізді микрочиптер
Энзимодиагностика
Қорытынды
Пайдаланылған әдебиеттер

Биотехнологияның қарқынды дамып келе жатқан бағыты - биоэлектроника - биологиялық организмдердің құрылымдары жəне электронды құрылымдарымен тығыз байланысты. Оларға: биологиялық сенсорлар (биосенсор), биологиялық микрочиптер (биочиптер), биотесттер жатады. «Биосенсор» деген терминді айқындайтын компоненттің болуын тікелей қоятын биологиялық материал: ферменттер, жасушалар, бактериялар, ашытқы, антигендер, антиденелер, липосомалар, органеллалар, рецепторлар, ДНҚ бар сезімді қабат. Конструкциялық түрде биосенсор - бір-бірімен тығыз байланыстағы екі биохимиялық жəне физикалық түрлендірігіш немесе трансдюсерден тұратын құрамдас құрылғы. Қазіргі уақытта биосенсорлардың бірнеше түрлері бар. Олардың қатарында - хеми- жəне биолюминисценция негізіндегі ферменттік электродтар, ферменттік микрокалориметрлік датчиктер жəне биодатчиктерді айтуға болады. [1]


Биологиялық микрочиптер - əртүрлі биохимиялық талдауларды жүргізу үшін қолданылатын кішкентай құрылғылар. Бұл - талданатын нұсқалар құрамындағы кез-келген заттармен өзара əрекеттесе алатын, реакцияға қабілетті агенттер түрлері салынған микропластинкалар. Оларда талданатын ерітпелерде бар заттардың молекуларын іріктеп байланыстыратын функциональдық жағдайдағы биологиялық белсенді макромолекулалар химиялық байланған. Биочиптің құрамына келетін болсақ, көптеген көзге əрең көрінетін, əрқайсысының диаметрі 100 микроннан кіші, жартылай сфералық гидрогендік ұяшықтарға салынған, үлкен емес əйнектен жасалған пластинкадан тұрады. [1]
Биоселективтік датчиктерін ионоселективті электродтар бетіне бүкіл микроорганизмдер жасушаларын немесе ұлпаларын жұқтыру арқылы жасайды. Мысалы, Neurospora europea бактерияларын NH3, ал сірке қышқылын анықтау мақсатында Trichosporon brassiacae пайдаланылады. Сонымен бірге сенсорлар ретінде өте жоғары сезімталдық қабілетке ие болып табылатын моноклональді антиденелері де пайдаланылады. Биодатчиктер мен биочиптерін жасауда əлемдегі жетекші орындарды Hitachi, Sharp сияқты Жапон компаниялары алады. [1]

Ғалымдар əртүрлі заттарды жылдам жəне өте нақты айқындауға мүмкіндік беретін биочиптік-тест жүйелерін ойлап шығарды. Кейбір аурулардың бастапқы кезеңдерінде ақуыз қатарында аздаған өзгерістер болып жатады. Осындай өзгерістерді дер кезінде байқап, алдын-ала профилактикалық шараларды жасау үшін өте қажетті болып табылатын жаңа ғылым саласы - протеомика, ақуыздарды зерттеуге, олардың тірі организмдердегі синтезіне, бір-бірімен өзара əрекеттесуіне жəне күрделі қатынастарға негізделетіні жөнінде оқулық материалдарының келесі тарауларында толықтай беріледі. Ресейлік жəне француз ғылымдары ақуыздардағы өзгерістерді табуға жəне талдауға қабілетті қондырғылар жасауда. [2]

Ақуыздық микрочиптерді əзірлеу өте күрделі жұмыс болып табылғандықтан, үлкен инвестициялар тартуды қажет етеді. Қазіргі кезде «Сiphergen Inc» компаниясы ең танымал ақуыздық чип шығарушы болып танылады. Бұл компания хроматографиялық ақуыздық чиптер мен масс. спектрометрлік детекторды (анықтаушы) байланыстыратын қондырғы жасап шығарды (Protein Chip System) . Аталған жүйе күрделі биологиялық ортадағы паталогиялық жағдайдағы биомаркерлерді іздейді. Бірінші топ - ДНҚ-чиптерінің миниатюралық құрылымы жасалып, моноклональді антиденелер немесе олардың аналогы маркерлерге микроөріс құруға қолданылады. [2]

Қазіргі кезде, өткізгіштік қасиетін ақуыз молекуласы атқаратын, жартылай өткізгіштіктер типтері жасап шығарылуда. Осындай ферменттік негізден тұратын жүйелердің, кремнийден жасалынатын өткізгіштерімен салыстырғанда, жоғары қабілетке ие екендіктері анықталған. Мұндай биочиптер шағын көлемді, сенімді жəне өздігінен ұйымдасуға қабілетті болып келеді. Мəселен, Sony деген Жапон компаниясы, бактериялар өнімі болып табылатын, целлюлозадан жасалынатын жоғары акустикалық қабілетке ие жүйелерін ойлап тапқан. Гель тəрізді целлюлоза арнайы кептіріледі. Осындай өнім құрылысы бойынша көптеген майда ұяшықтардан (сот) тұруы себепті, акустикалық жүйелерге лайықты жалпақ диафрагма ретінде пайдаланылады. [2]

Энзимологияның қазіргі кезендегі ғылыми жетістіктері көптеген аурулардың дамуы механизмдерін түсінуге ықпал жасайды және практикалық медициналық энзимодиагностика, энзимо-, коэнзимотерапия бөлімдерінің кең қолданылуына жағдай жасады.
Энзимодиагностика. Қазіргі заманғы клиникалық биохимия ұлпалардың, торшалардың, биосұйықтықтардың ферменттерінің активтілігін анықтаудың әртүрлі тәсілдерін кең қолданады. Бұл ағзаның диагностикасы үшін аса маңызды және көптеген аурулардың дамуының механизмі мен дифференциалды диагностикасы үшін ыңғайлы әдістерді береді. [3]

Энзимодиагностика тәсілдері екі түрлі аспектіге бөлінеді:
1. Лабораториялық диагностикада ферменттерді аналитикалық реагент ретінде пайдалану. Бұл жолдар арқылы глюкозаны, этанолды, зәр қышқылын және т. б. анықтауға болады. Анықтау кезінде иммобилденген ферменттерді (ферменттер ерітілген күйде болады) мембранамен байланысқан ферменттерді пайдаланады. Олар биохимиялық автоматтардың құрам бөліктеріне жатады.
2. Биологиялық материалдардағы ферменттердің активтілігін анықтау.
Энзимодиагностиканың теориялық негізіне ферменттердің ағзадан тысқары болғанда активтілігін тежеуі, субстраттық талғамдылық пен әсер ету талғамдылықтарының тежелуі жатқызылады. Торшалардың әртүрлі мүшелері, ұлпалары мен органеллалары ферменттік және изоферменттік спектрлерімен сипатталады. Сонымен бірге кейбір ауруларда фермент активтілігінің өзгерісінің патогенетикалық өзгеруі де байқалады.
Әртүрлі мүшелерге әртүрлі ферменттік құрамы тән болғандықтан, оларды, мүшеспецификалық ферменттер ретінде қарастыруға болады. Сондықтан, сол мүшелерге тән ферменттік өзгерісті анықтаған соң бір науқастың бауырының зақымдалғанын, ал келесі науқастың басқа бір мүшелерінің бұзылатынын анықтауға болады. Және бұл клиникалық белгілерінсіз ақ түсініксіз диагнозды анықтауға мүмкіндік береді. [3]

- Іс жүргізу
- Автоматтандыру, Техника
- Алғашқы әскери дайындық
- Астрономия
- Ауыл шаруашылығы
- Банк ісі
- Бизнесті бағалау
- Биология
- Бухгалтерлік іс
- Валеология
- Ветеринария
- География
- Геология, Геофизика, Геодезия
- Дін
- Ет, сүт, шарап өнімдері
- Жалпы тарих
- Жер кадастрі, Жылжымайтын мүлік
- Журналистика
- Информатика
- Кеден ісі
- Маркетинг
- Математика, Геометрия
- Медицина
- Мемлекеттік басқару
- Менеджмент
- Мұнай, Газ
- Мұрағат ісі
- Мәдениеттану
- ОБЖ (Основы безопасности жизнедеятельности)
- Педагогика
- Полиграфия
- Психология
- Салық
- Саясаттану
- Сақтандыру
- Сертификаттау, стандарттау
- Социология, Демография
- Спорт
- Статистика
- Тілтану, Филология
- Тарихи тұлғалар
- Тау-кен ісі
- Транспорт
- Туризм
- Физика
- Философия
- Халықаралық қатынастар
- Химия
- Экология, Қоршаған ортаны қорғау
- Экономика
- Экономикалық география
- Электротехника
- Қазақстан тарихы
- Қаржы
- Құрылыс
- Құқық, Криминалистика
- Әдебиет
- Өнер, музыка
- Өнеркәсіп, Өндіріс
Қазақ тілінде жазылған рефераттар, курстық жұмыстар, дипломдық жұмыстар бойынша біздің қор #1 болып табылады.



Ақпарат
Қосымша
Email: info@stud.kz